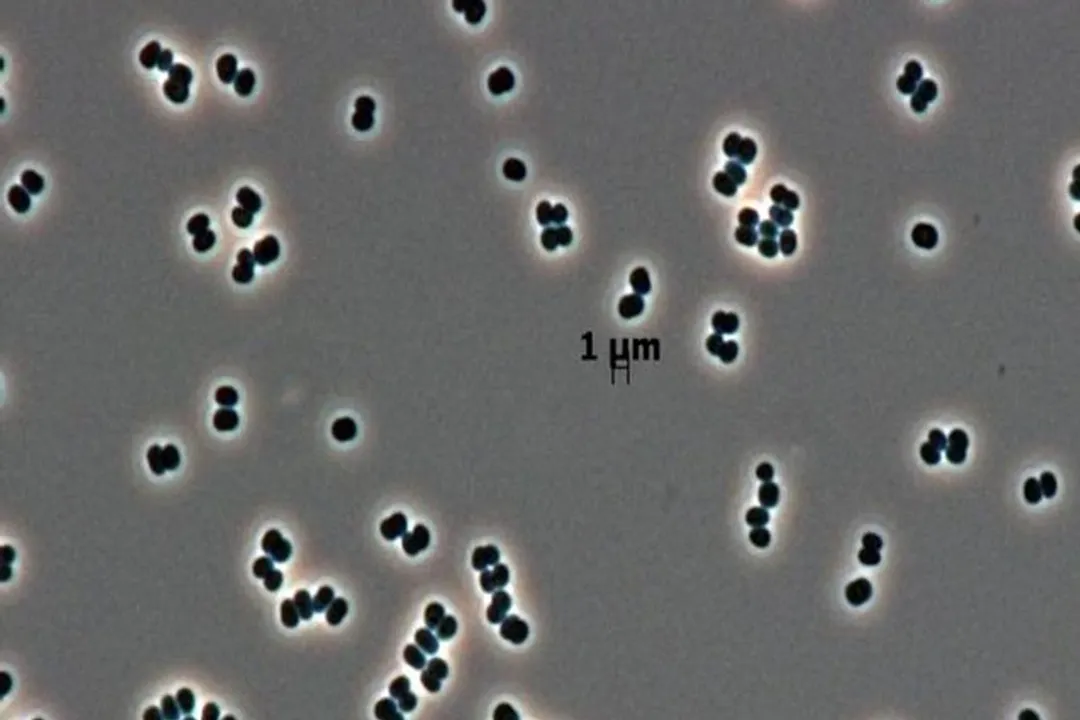

What is the essential nature of the survival state observed in terrestrial bacteria in NASA assembly environments?
Answer
A near-total metabolic shutdown rendering them nearly invisible to detection
The state observed is described as a profoundly dormant state involving an almost complete halt in cellular activity, allowing them to effectively 'play dead' to conserve energy until conditions improve.
Related Questions
What is the essential nature of the survival state observed in terrestrial bacteria in NASA assembly environments?What is the primary goal of the strict standards maintained in the specialized clean rooms?What characteristic makes these deep-dormant microbes difficult to detect using traditional methods?How does the observed extreme persistence behavior fundamentally differ from typical bacterial spore formation?What risk does the gap between *culturable* microbes and *truly viable* microbes pose for planetary missions?What specific environmental challenges might these resilient organisms need to survive during interplanetary travel?What principle mandates strict adherence to preventing biological cross-contamination between Earth and other worlds?What must spacecraft designers account for concerning these persistent organisms for future habitable world missions?Which capability do these bacteria demonstrate concerning the stringent cleaning processes in assembly facilities?What advancement does the existence of deep-dormant microbes suggest needs increased priority for future planetary probes?